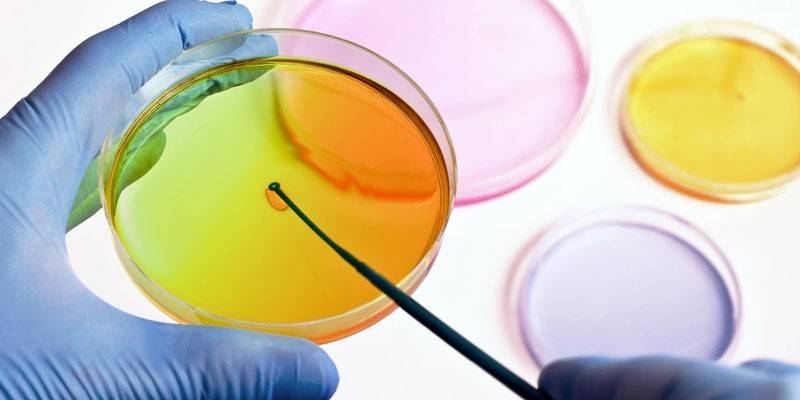

Wysiew moczu w czasie ciąży - wskazania do stosowania, przygotowania i pobierania materiału, interpretacja wyników
Podczas ciąży szczególnie ważne jest monitorowanie stanu zdrowia matki i dziecka. W tym celu każda kobieta od 10 tygodnia ciąży powinna zarejestrować się w ginekologu-położniku w przychodni przedporodowej, regularnie odwiedzać lekarza i poddawać się wszystkim przepisanym testom i badaniom. Obowiązkowe procedury obejmują ogólne badania kliniczne krwi i moczu, ultradźwięki, biochemiczne markery genetyczne, próbki krwi na zakażenie wirusem HIV, kiłę i zapalenie wątroby, a także analizę moczu w przypadku pieczenia w czasie ciąży.
Czym jest kultura moczu podczas ciąży
Bakteriologiczna hodowla moczu jest badaniem przeprowadzanym wyłącznie w laboratorium bakteriologicznym i ma na celu identyfikację patogennych mikroorganizmów w moczu. Z reguły wysiew u kobiet w ciąży odbywa się wraz z badaniem wrażliwości zidentyfikowanych mikroorganizmów na antybiotyki, podczas gdy możliwe jest określenie wrażliwości drobnoustrojów zarówno na główne grupy antybiotyków, jak i na leki o szerokim spektrum działania, w tym leki przeciwgrzybicze.
Oprócz dwóch obowiązkowych badań zaleca się hodowlę moczu pod kątem bezpłodności w czasie ciąży, gdy istnieją podejrzenia chorób układu moczowego lub bakterie w moczu są wykrywane w ogólnej analizie. Normalny mocz jest sterylnym płynem i nie zawiera żadnych mikroorganizmów. Z powodu niedokładności w zbieraniu materiału lub niewystarczającej sterylności pojemnika do próbki może dostać się pewna ilość bakterii. Z tego powodu, jeśli niewielka ilość zostanie wykryta w moczu, wynik uważa się za ujemny.
Dlaczego kultura moczu podczas ciąży
Badanie bakteriologiczne moczu u kobiet w ciąży ujawnia patogeny wywołujące choroby układu moczowo-płciowego u pacjentów. Badanie obejmuje określenie wrażliwości flory chorobotwórczej na różne leki przeciwbakteryjne. Mocz do siewu w czasie ciąży jako test profilaktyczny podaje się dwukrotnie - po zarejestrowaniu u ginekologa-położnika w przychodni przedporodowej i przed porodem.
Kto ma przypisaną analizę
Pieczenie w czasie ciąży jest obowiązkowym badaniem i odbywa się w pierwszym i trzecim trymestrze ciąży w 10-12 i 36-38 tygodniu. Poza tym obowiązkowa podwójna analiza istnieją szczególne wskazania do posiewu bakteriologicznego moczu podczas ciąży:
- ból pleców i / lub oddawanie moczu;
- zwiększona częstotliwość oddawania moczu;
- niska temperatura (od 37,0 do 37,9 ° C);
- obecność ustalonej diagnozy lub podejrzenia cukrzycy;
- podejrzenie gruźlicy;
- nietypowy przebieg chorób;
- historia spontanicznych poronień;
- dzieci z poprzednich ciąż z wadami wrodzonymi;
- szkodliwe warunki pracy;
- monitorowanie skuteczności przepisanej terapii lekowej.
Jak przygotować się do badania
Przygotowanie do badania bakteriologicznego moczu pod kątem bezpłodności u kobiet w ciąży nie stanowi szczególnych trudności i ma ogromne znaczenie. Dokładność i poprawność wyników badania zależą od prawidłowo przeprowadzonego przygotowania do analizy. Aby wyniki analizy były dokładne, należy przestrzegać następujących zasad:
- 3)i na tydzień przed przystąpieniem do testu zaleca się ograniczenie spożycia słonych i tłustych potraw.
- Na 2 dni przed testem należy przerwać przyjmowanie leków moczopędnych, ziołowych, ludowych o działaniu moczopędnym i stosowanie czopków dopochwowych.
- Bezpośrednio przed pobraniem moczu do siewu bakteryjnego należy wykonać dokładną toaletę zewnętrznych narządów płciowych.
- Do badania pobierana jest tylko średnia porcja moczu rano.
- Materiał jest gromadzony przed przepisywaniem i przyjmowaniem antybiotyków.
- Pojemnik na badany materiał musi być sterylny.
Jak wziąć
Prawidłowo wykonany zbiór materiału do badań bakteriologicznych jest kluczem do jego wiarygodnego wyniku. Aby zebrać mocz, potrzebujesz czystego, suchego słoika lub specjalnego pojemnika medycznego do analizy. Lepiej jest preferować pojemnik medyczny, ponieważ są one sterylne, a to zmniejsza ryzyko fałszywych wyników.
Przed pobraniem moczu do posiewu dokładnie umyj ręce, umyj genitalia ciepłą wodą z mydłem i osusz je czystym ręcznikiem. Do pochwy należy włożyć sterylny wacik, aby zapobiec przedostawaniu się wydzieliny z pochwy i mikroflory do moczu w celu zaszczepienia. Tylko mocz od pierwszego porannego oddawania moczu nadaje się do siewu. Technika pobierania moczu do pieczenia:
- Przez około 1-3 sekund pacjent powinien wypuścić pierwszy strumień moczu do muszli klozetowej i przestać oddawać mocz, aby przepłukać cewkę moczową.
- Otwórz sterylny pojemnik.
- Zbierz 50–100 ml moczu do pojemnika i szczelnie zamknij.
- Całkowite oddawanie moczu w toalecie.
- Dostarcz pojemnik do laboratorium 1-2 godziny po pobraniu.

Nie zaleca się pobierania moczu przeznaczonego do zaszczepienia z naczynia lub pisuaru, aby uniknąć niewiarygodnych wyników. Cewniki moczowe nie powinny być stosowane podczas pobierania materiału u kobiet w ciąży, ponieważ może to przyczynić się do infekcji dróg moczowych. Na dzień przed pobraniem moczu do wysiewu kobiety w ciąży aktywność fizyczna powinna być ograniczona, ponieważ mogą one prowadzić do zwiększonego wydalania białka, a tym samym zniekształcać wyniki badania.
Dekodowanie kultury moczu
Bakteriuria rozwija się 5 razy częściej u kobiet w ciąży niż u kobiet niebędących w ciąży. Ponadto u 20–40% pacjentów obserwuje się bezobjawowe wydalanie bakterii, które nie ma objawów klinicznych. W przypadku braku odpowiedniego leczenia stan ten bardzo często przechodzi w odmiedniczkowe zapalenie nerek, zapalną chorobę nerek, która jest niebezpieczna dla życia matki i płodu, ponieważ istnieje wysokie prawdopodobieństwo rozprzestrzeniania się infekcji z dróg moczowych do układu rozrodczego. Kiedy patogen wchodzi do macicy przez kanał szyjki macicy, płód zostaje zarażony.
W przypadku siewu bakteryjnego częściej wykrywane są patogenne mikroorganizmy, takie jak enterokoki, Escherichia coli, Klebsiella i Pseudomonas aeruginosa. Nieco rzadsze są infekcje wywołane przez Staphylococcus aureus, protea lub grzyby. PCR jest niezbędny do wykrycia patogenów zewnątrzkomórkowych, takich jak E. coli, grzyby, pierwotniaki lub ziarniaki (gronkowce, enterokoki).
Ilość bakterii wydalanych z moczem jest mierzona za pomocą wskaźnika ilościowego - CFU (jednostka tworząca kolonię) w jednym ml badanego materiału. Jednostką tworzącą kolonię jest jedna komórka drobnoustrojowa zdolna do utworzenia kolonii na pożywce. Określenia wrażliwości patogenu dokonuje się dopiero po otrzymaniu wątpliwego lub pozytywnego wyniku testu. Leczenie jest zalecane tylko przy dodatniej posiewie moczu u kobiety w ciąży.
|
Wynik |
Bakterie się liczą |
Skrót |
Interpretacja |
|
Wynik ujemny (norma) |
Mniej niż 1000 jtk / ml |
≤103 CFU / ml |
Ciężarne bakterie przypadkowo uwięzione w próbce moczu. Nie ma stanu zapalnego w układzie moczowym. |
|
Wątpliwy wynik |
1000 - 100000 CFU / ml |
103 - 105 CFU / ml |
Istnieje ryzyko procesu zakaźnego. Wymagana jest powtarzana analiza. |
|
Wynik pozytywny |
Co najmniej 100 000 CFU / ml |
≥105 CFU / ml |
W drogach moczowych koncentruje się infekcja spowodowana wykrytym patogenem. |
Cena

Hodowla moczu z określeniem wrażliwości patogenu na antybiotyki może mieć zmienną cenę, w zależności od tego, jakie laboratorium zostanie przeprowadzone. Tabela pokazuje koszt badania w różnych centrach medycznych i laboratoriach w Moskwie:
|
Nazwa laboratorium |
Cena badania z określeniem wrażliwości na główne spektrum antybiotyków, rubli |
Cena badania z określeniem wrażliwości na rozszerzone spektrum antybiotyków, ruble |
|
LLC „INVITRO” |
910 |
1855 |
|
Medical Women's Center LLC |
– |
1500 |
|
Centrum Medyczne „Nowe technologie medyczne” |
790 |
1260 |
|
Centrum medyczne „He Clinics” |
750 |
– |
|
Płatne Centrum Medyczne Dermatologii i Wenerologii |
1000 |
– |
|
Grupa KDL Kliniczne laboratoria diagnostyczne |
1178 |
1145 |
|
Gemotest Laboratory LLC |
1000 |
1200 |
|
Klinika medycyny i urody na Paveletskaya |
1070 |
– |
|
ММЦ „Medkvadrat” |
970 |
1100 |
|
LLC Medical Center |
660 |
– |
|
Centrum Medyczne „MobilMed” |
730 |
1000 |
|
FBUN Centralny Instytut Badawczy Epidemiologii Rospotrebnadzor |
1020 |
1300 |
|
LLC „MEDOK” |
1240 |
– |
|
MBC „Pasteur” |
– |
1800 |
|
MC „Imed” |
680 |
870 |
|
LLC Clinic „Crede Expert” |
1000 |
1200 |
Wideo
 W jaki sposób rezygnuje się z bakteriologicznej hodowli moczu?
W jaki sposób rezygnuje się z bakteriologicznej hodowli moczu?
